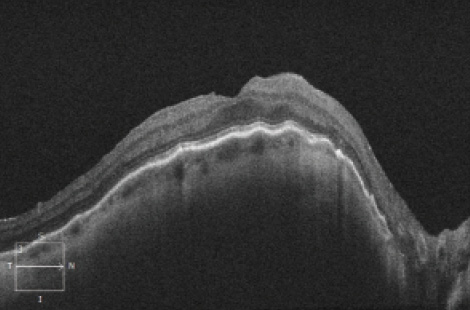

We sometimes encounter cases that seem to have one problem after another. It’s important to reevaluate the problem and any new ones that arise at each step in order to plan further management. One such case is described below and highlights the need to change management if necessary and make use of new information as it is available.
AT A GLANCE
• Patients with high myopia are more prone to hypotony maculopathy even at physiologic IOP (especially following pars plana vitrectomy) and may be poor candidates for an iris-sutured IOL due to iridodonesis.
• The ocular endoscope system is helpful in determining the cause of persistent uveitis-glaucomahyphema syndrome.
• Long-term anticoagulant therapy is a risk factor for uveitis-glaucoma-hyphema syndrome, and alternate therapies may be required to prevent hemorrhage.
The Case
A 62-year-old man presented to my clinic with suddenly decreased vision in one eye. Because he was a surgeon, he was unable to work. His ocular history was significant for uncomplicated phacoemulsification surgery approximately 8 years prior. His medical history was significant for atrial fibrillation requiring long-term anticoagulation with warfarin. The patient’s BCVA was 20/20 in the unaffected eye and count fingers at 4 feet in the affected eye. The IOL was dislocated in the capsular bag and was now in the vitreous space. The optic nerves were normal but with tilting and peripapillary atrophy. Owing to the presence of a large Soemmering ring in the capsule, my colleague and I decided to perform a vitrectomy with removal of the lens capsule and iris suturing of the dislocated three-piece acrylic IOL. The surgery was uneventful and included a 23-gauge pars plana vitrectomy performed by my retina colleague, removal of the Soemmering ring tissue and capsule, and iris suture fixation of the IOL with two McCannel sutures. On the first postoperative day, the patient’s UCVA was 20/200, the IOL was well centered, the vitreous was clear, and corneal edema was mild with Descemet membrane folds. The IOP was 4 mm Hg with a deep and formed anterior chamber. The patient began instilling antibiotic and steroid drops four times a day.
Figure 1. Optical coherence tomography of the macula showing choroidal folds from hypotony maculopathy.
The corneal edema cleared within 1 week, but the patient’s BCVA remained 20/200. The cause was determined to be hypotony maculopathy, confirmed by a fundoscopic exam and macular optical coherence tomography (Figure 1). There was no wound leak, so I assumed that there was a slow leak via one of the sclerotomies. I recommended observation, as the condition would likely improve on its own.
The IOP did rise slightly over the next 2 months to physiologic levels (4-8 mm Hg), but the hypotony maculopathy and poor vision remained. After 2.5 months, I decided to temporarily raise the IOP in an effort to flatten out the choroidal folds. I filled the anterior chamber 50% with a high-molecular-weight viscoelastic and performed an intravitreal injection of triamcinolone acetonide (Kenalog; Bristol-Myers Squibb). The next day, the IOP rose to 50 mm Hg with pain, and the patient’s UCVA decreased to count fingers. Despite maximum topical and oral glaucoma medication and the release of aqueous via a paracentesis, the IOP returned to 50 mm Hg the next day. I treated the patient with repeated release of aqueous over the course of the next 2 days, but the high IOP did not break. I proceeded with an orphan trabeculectomy (performed without antifibrotics). My goal was to lower IOP temporarily, with planned eventual failure. This procedure reduced the IOP to 10 to 20 mm Hg, and the choroidal folds eventually resolved. The patient’s UCVA remained at 20/200 or worse, however, and I noted pigment dispersion with anterior chamber diffuse microhyphema as well as vitreous hemorrhage. When the vitreous hemorrhage did not clear, my retina colleague performed a washout with vitrectomy. With the IOP normalized and the blood cleared, the patient’s UCVA returned to 20/40. After 2 weeks, however, the hemorrhage returned, and the UCVA dropped back to between 20/400 to count fingers.

Figure 2. Anterior chamber hemorrhage prior to the first washout procedure.

Figure 3. Ultrasound biomicroscopy of the iris-sutured IOL shows significant contact with the iris, causing trauma with pigment dispersion and recurrent hemorrhage.
I diagnosed uveitis-glaucoma-hyphema (UGH) syndrome, likely caused by the iris-sutured IOL’s rubbing on the posterior iris surface (Figures 2 and 3). Another washout was performed as well as an IOL exchange. To move the IOL away from the iris, I replaced the iris-sutured IOL with a sclera-sutured lens. The patient’s UCVA improved to 20/50, but 2 weeks later, the hyphema and vitreous hemorrhage returned. The IOP began to rise into the high 20s despite maximum topical glaucoma medications.
Three months later, I returned to the OR to perform a washout but this time with intraoperative endoscopy to determine the cause of the recurrent hyphema. Using the endoscope (BVI), I found a retained segment of the iris-sutured IOL’s haptic stuck in the pars plana in an area surrounded by hemorrhage (Figure 4). After the fragment’s removal, my retina colleague performed retinal cryotherapy to the area to seal any abnormal vessels. I placed an Ahmed Glaucoma Valve (New World Medical) to control IOP and allow egress of any recurrent microhyphema.
I felt confident that removal of the retained haptic and retinal cryotherapy would cure the UGH syndrome, but a week after the patient resumed warfarin therapy, the hemorrhage returned. I discussed with the patient the possibility of discontinuing the medication and, after consultation with his cardiologist, determined that doing so would require the placement of a left atrial appendage device. The Watchman Device (Boston Scientific) is used to close off the left atrial appendage, the site of 90% to 95% of blood clots in atrial fibrillation (Figure 5). It is being used as an alternative to long-term anticoagulant therapy.1 The patient underwent the Watchman procedure and was able to discontinue warfarin 6 weeks later. After two months, his UCVA began to improve from hand motion to 20/800. In another month, it had increased to 20/60 (latest follow-up). I hope that the patient’s UCVA will eventually improve to the 20/40 level or better with complete resolution of the vitreous hemorrhage and that it will remain clear thanks to the absence of an anticoagulated state.

Figure 4. Endoscopy reveals a retained foreign body (lens haptic) in the pars plicata adjacent to an area of hemorrhage (A). Removal of the remnant with microforceps under endoscopic guidance (B).
Background
UGH syndrome and its close relative, secondary pigment dispersion syndrome, are most often associated with problems related to IOL implantation. UGH syndrome was first described in 1978 as an “intraocular chafing” with release of pigment and recurrent hemorrhage with an associated rise in IOP.2 The condition is usually caused by repetitive injury to the iris from a malpositioned lens implant’s optic or haptic.3 The most common sites of contact are the posterior iris pigment epithelium and the pars plicata. UGH syndrome is associated with excessive movement of the IOL or, in the case of old lens designs, with poorly fabricated edges or rigid, closed-loop haptics. The condition was first described with anterior chamber lenses but was eventually seen with malpositioned posterior chamber lenses as well.4 The risk is likely increased with systemic anticoagulation.5 Symptoms include decreased vision because of bleeding, pigment dispersion, or corneal edema. The problem waxes and wanes but can become permanent with optic nerve or corneal damage as well as nonclearing vitreous hemorrhage. Ocular signs include anterior chamber and vitreous hemorrhage, increased IOP, and typical glaucomatous optic neuropathy. There may be evidence of pigment dispersion in the angle and cornea (Figure 6) as well as transillumination defects of the iris (Figure 7). Corneal edema is caused by elevated IOP and, over time, can result in corneal blood staining. Chronic inflammation leads to signs of anterior uveitis and, eventually, cystoid macular edema.

Figure 5. Watchman Device to close the left atrial appendage to prevent clotting due to atrial fibrillation.
Medical management includes topical steroids for inflammation and topical and oral glaucoma medications for lowering the IOP. Topical mydriatics are commonly used to control pain and reduce rubbing of the iris on the offending implant. Depending on the location of the IOL, miotics can alternatively be used to prevent contact. Dilated gonioscopy, ultrasound biomicroscopy,6 and intraoperative endoscopy are helpful for diagnosing the cause of the problem and planning surgical management. Most patients will require surgery to address the cause of the trauma. It may involve IOL rotation, partial or complete removal, or replacement with a sulcus-placed three-piece IOL or a scleral fixated or anterior chamber IOL.7 The intervention must be tailored to the specific type and location of the problem. Surgery to manage the glaucoma can involve angle-based microinvasive glaucoma surgery, endoscopic cyclophotocoagulation, or traditional glaucoma filtration surgery (trabeculectomy or aqueous tube shunt).

Figure 6. Pigment deposition in the angle as a result of UGH syndrome from IOL chafing of the iris.

Figure 7. Transillumination defect of the iris from a malpositioned IOL haptic.
Lessons Learned
In retrospect, it might have been preferable to perform in-the-bag scleral fixation of the IOL with a limited anterior vitrectomy if needed. This would have avoided the later problems of hypotony and UGH syndrome. The decision we made was based on the large Soemmering ring and a concern that this tissue would rub on the peripheral iris.High myopia contributed to the hypotony maculopathy, which persisted despite an IOP in the normal range (8 mm Hg). The high myopia was also associated with a floppy iris, making the iris-sutured IOL more prone to cause pigment dispersion and iris trauma.
Temporary elevation of the IOP is an effective treatment for choroidal folds and hypotony but, in this case, resulted in an extremely high IOP that was refractory to medication and the repeated release of viscoelastic and aqueous. I performed an orphan trabeculectomy to temporarily decrease IOP and prevent optic nerve damage or retinal vascular occlusion. I chose this approach over an aqueous tube shunt to avoid permanent IOP lowering and implantation of a device. With the recurrence of hemorrhage and high IOP more than a year later, an Ahmed valve was required. I chose this implant over a nonvalved implant such as a Baerveldt glaucoma implant (Abott Medical Optics) to give immediate IOP lowering and because of the valve mechanism’s helping to prevent hypotony.
I replaced the iris-sutured IOL with a sclera-sutured IOL to move the lens posteriorly away from the iris, but a fragment of IOL haptic was left in the eye. Despite searching for the haptic, I could not find it and presumed it was still attached to the iris. Use of the ocular endoscope at this juncture might have helped in locating and removing the fragment. During the subsequent surgery, my use of the endoscope was critical in identifying and retrieving this piece. I learned that earlier use of the ocular endoscope may be warranted in certain cases.
Finally, despite removal of the suspected causes of trauma, the patient continued to have bleeding and decreased vision. We had treated with retinal cryotherapy of the pars plana at the site of the retrieved haptic and at the scleral fixation sites to seal any abnormal blood vessels. We noted that the patient’s vision was good after every washout procedure, but the bleeding returned after resuming the warfarin. Of note, the Watchman device implantation and cessation of anticoagulation seems to have prevented recurrence of the hemorrhage. In similar cases, we may now sooner consider alternatives to anticoagulation. We are optimistic after 3 months of clearing of the hemorrhage and improvement in visual acuity.
1. Sick PB, Schuler G, Hauptmann KE, et al. Initial worldwide experience with the Watchman left atrial appendage system for stroke prevention in atrial fibrillation. J Am Coll Cardiol. 2007;49(13):1490-1495.
2. Brodstein RS. Hyphema syndrome with anterior lenses. J Am Intraocul Implant Soc. 1978;4(1):64-65.
3. Ellingson FT. The uveitis-glaucoma-hyphema syndrome associated with the Mark VIII anterior chamber lens. J Am Intraocular Implant Soc. 1978;4(2):50-53.
4. Aonuma H, Matsushita H, Nakajima K, et al. Uveitis-glaucoma-hyphema syndrome after posterior chamber intraocular lens implantation. Jpn J Ophthalmol. 1997;41(2):98-100.
5. Angunawela R, Hugkulstone CE. Uveitis-glaucoma-hyphema syndrome and systemic anticoagulation. Eye. 2005;19(2):226-227.
6. Piette S, Canla OA, Tran HV, et al. Am J Ophthalmol. 2002 ;133(6):839-41.
7. Sinskey RM, Amin P, Stoppel JO. Indications for and results of a large series of intraocular lens exchanges. J Cataract Refract Surg. 1993;19(1):68-71.
Section Editor Leon W. Herndon, MD
• professor of ophthalmology, Duke University of Eye Center, Durham, North Carolina
• (919) 684-6622; leon.herndon@duke.edu
Brian A. Francis, MD, MS
• health sciences professor of ophthalmology and Rupert and Gertrude Stieger endowed chair, Doheny and Stein Eye Institutes, David Geffen School of Medicine, University of California, Los Angeles
• bfrancis@doheny.org
• financial disclosure: consultant to BVI

